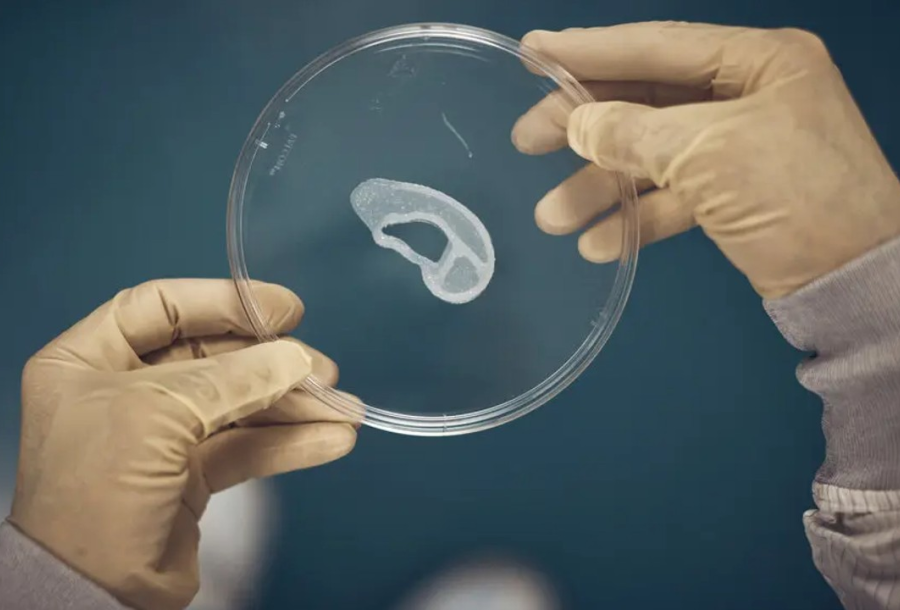
Tıp Dünyasında Yenilik: 3D Sayesinde Kulak Elde Edildi!

JESTSEL İPUCU
Öğrenciden ne istediğini bekler yüz ifadesi, başını ya da vücudunun çocuğa, araçlara ya da etkinliğe doğru hareket ettirmeyi içeren ipuçlarına jestsel ipucu denir.
Jestsel ipuçları genellikle diğer ipucu türleri ile birlikte kullanılmaktadır. İpuçları için yapabilecek bir sınıflandırma ipucunu sınırlayıcılığına ilişkindir.
En ılımlı ya da en az sınırlayıcı olan ipucu jestsel ipuçlarıdır.
Jetsel müdahaleci olmayan doğal ipuçlarıdır. Dudaklarını kapatarak işaret parmağının dudaklarını götürmüş bir uygulamacı öğrencilerden sessiz olmalarını jestsel ipucu vererek istemektedir.
Bu ipucunu kullanmanın çeşitli yararları bulunmaktadır. Jestsel ipuçlarını kullanmak kolaydır, bir grup öğrenci ile bir sefer de kullanılabilirler ve öğrencilere dokunmayı gerektirmez. Ancak jestsel ipucunun en önemli sınırlılığı öğrencilerin jestin içeriğini anlamama olasılığıdır.